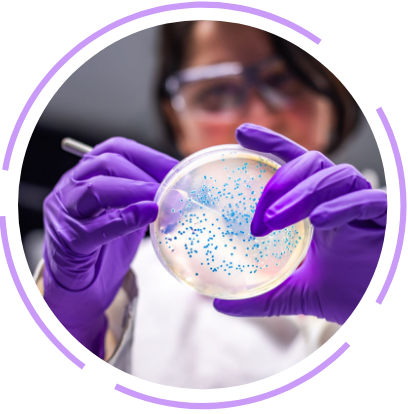

Ingenuity That Reduces Unpredictability
It takes skill and expertise to navigate a microbial molecule from concept to development. Through our experience in establishing the KeystoneTM Expression System and moving dozens of microbial projects to cGMP manufacturing, we have gained a thorough understanding of critical parameters in the microbial development process that can reduce unpredictability and increase productivity at a larger scale. With our Keystone™ Expression System coupled with our fermentation, refold, downstream and analytical expertise, we keep your molecule moving forward and provide immediate solutions if surprises occur.
